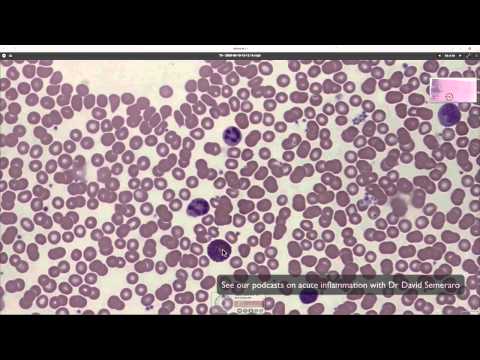

This is just a brief video and overview on how to differentiate lymphocytes and monocytes morphologically on a peripheral blood smear. I also included blasts just to compare more of their characteristics. Resources for this channel available on my Amazon storefront: 🔗 Stay Connected: 📸 Instagram: @ 🎵 TikTok: @ 📧 Contact: @ Disclosure: The above link helps run this channel without any additional cost to you.❤️ ------------------------------------------- Hi I'm Rea! Welcome to my channel, I mainly focus on Hematology where I try to simplify concepts and give memorization techniques, but I do branch out every now and then, and share my life as a Clinical Lab Scientist. Depending on how busy I get, I may get delayed in uploading so please bear with me. I do appreciate the comments and I try to read and reply to them when I can. If you are struggling on a certain topic don't be shy to leave a comment down below, and I'll see what I can do. If my content is helpful for you, come join me and please do like and subscribe! 😊 Thank you for spending your time with me today, and have a nice day! 😁